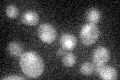
YNL218W
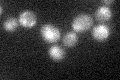
YNL218W

View description
Protein with DNA-dependent ATPase and ssDNA annealing activities involved in maintenance of genome; interacts functionally with DNA polymerase delta; homolog of human Werner helicase interacting protein (WHIP)
Localization:
Intensity:
Fold change:
Significance:
-
C’ GFP library in SD
nucleus19.1 -
N' NOP1pr-GFP in SD

nucleus72.9667 -
N' TEF2pr-mCherry in SD

nucleus78.7389 -
N' NATIVEpr-GFP in SD

punctate,nucleus24.544 -
N' TEF2pr-VC and Cyto-VN in SD

punctate,nucleus30.5068 -
C’ GFP library in SD+DTT

nucleus20.531.07No -
C’ GFP library in SD+H2O2
nucleus17.870.93No -
C’ GFP library in Starvation Media

nucleus17.860.93No -
C’ GFP library on the background of Pup2-DaMP

nucleus -
C’ GFP library on the background of CCT mutant

nucleus21.56261.12822No
